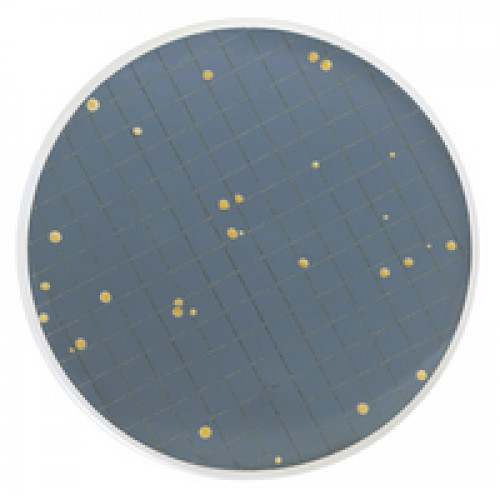
MEIO PRY EM AMPOLA 2ml PARA LEVEDURAS RESISTENTES A CONSERVANTES (CX) MILLIPORE MEIO PRY EM AMPOLA 2ml PARA LEVEDURAS RESISTENTES A CONSERVANTES (CX) MILLIPORE

MEIO PRY EM AMPOLA 2ml PARA LEVEDURAS RESISTENTES A CONSERVANTES (CX) MILLIPORE
Modelo: MHA00PRY2
-
R$1.193,17
ou até 3x de R$397,72 sem juros
Economize 5% no PIX: R$1.133,51
ou 3.5% no boleto: R$1.151,41
Descrição
MEIO PRY EM AMPOLA 2ml CX C/ 50 UND MILLIPORE
P/LEVEDURAS RESISTENTES A CONSERVANTES
P/LEVEDURAS RESISTENTES A CONSERVANTES